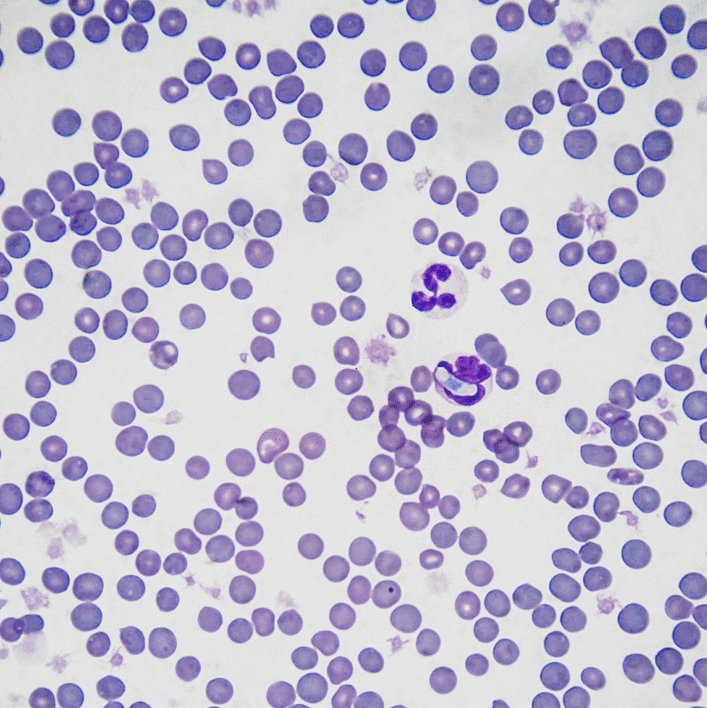

Abstract
Hepatozoon spp. is the causative agent of a vector-borne parasitic disease in many animal species. In felids, Hepatozoon felis, Hepatozoon canis and Hepatozoon silvestris have been molecularly isolated. Hepatozoonosis usually causes asymptomatic infections in domestic cats, but clinical cases have recently been reported in Europe. We describe the first Italian case of hepatozoonosis in a cat with an unusual presentation. An 11-year-old neutered European shorthair cat was urgently hospitalized for intestinal intussusception. Hematology, biochemistry, FIV-FeLV tests, blood smears and molecular investigation targeting the 18S rRNA gene of Hepatozoon spp. were performed on blood samples; in addition, histological and molecular investigations were performed to analyze surgical samples to identify Hepatozoon infection. Hepatozoon gamonts were detected in granulocytes in the blood smear, and Hepatozoon spp. DNA was confirmed by PCR on blood. The intussusception was caused by a sessile endoluminal nodule that was surgically removed. Histologically, many elements referring to parasitic tissue forms were identified in the intestinal cells, and then the specimens were molecularly confirmed to harbor H. silvestris. This is the first description of symptomatic hepatozoonosis in a domestic cat in Italy. Hepatozoon silvestris has been described in wild felids, which are usually resilient to the infection, whereas the domestic cat seems to be more susceptible. Indeed, H. silvestris in cats usually presents tropism for skeletal muscle and myocardium with subsequent clinical manifestations. This is the first description of a domestic cat with H. silvestris localized in the intestinal epithelium and associated with intussusception.
Graphical abstract
Keywords: Domestic cat, Infection, Intestinal nodule, Hepatozoon silvestris, Italy
Hepatozoonosis is a vector-borne disease affecting many of animals, including reptiles, birds and mammals; it is caused by an apicomplexan parasite, of which almost 340 species are currently described [1–3]. Almost 50 species are recognized in mammals [1], but comprehensive information regarding their life cycle is known for only a few of them. Usually, the Hepatozoon life cycle involves an intermediate and a definitive host represented by a vertebrate animal and an arthropod vector, respectively [4]. In contrast to other vector-borne protozoa (e.g. Babesia spp., Leishmania infantum) transmitted to humans and animals bitten by infected arthropods, in hepatozoonosis, the vertebrate host becomes infected through the ingestion of infected arthropods [1, 2]. In the vertebrate host, the asexual replication of Hepatozoon takes place, generating intracellular gamonts that circulate in the bloodstream. The vectors, mostly represented by ticks, ingest Hepatozoon gamonts through blood-feeding from infected animals, and sexual replication takes place within the ticks, ending in the production of mature oocysts that are ready to infect a new vertebrate host and complete the life cycle when the arthropod will be ingested [2]. Interestingly, other transmission routes have been reported, e.g. in the Hepatozoon canis and Hepatozoon felis life cycles, vertical intrauterine transmission is described, and in the Hepatozoon americanum life cycle, predation (i.e. the ingestion of infected prey) has been proven to be an additional transmission route [2, 5, 6].
In felids, hepatozoonosis is still mostly unknown worldwide, but recent epidemiological studies and case reports are raising attention about this parasite and its pathogenicity [7, 8]. Currently, three species of Hepatozoon are recognized in wild and domestic felids in Europe, i.e. Hepatozoon felis, Hepatozoon canis and Hepatozoon silvestris [3, 9–11], but no information about the involved arthropod vectors are available, even if ticks seem to be the most likely arthropod vector [12–15]. Usually, hepatozoonosis in domestic and wild felids is considered subclinical, despite replicative forms (i.e. meronts) being found in skeletal muscles and in the myocardium of infected felids [2, 16, 17]. Recently, two cats with clinical signs were described in Central Europe; the first cat was presented with severe and fatal myocarditis and H. silvestris infection [7], and the second cat was in poor general condition and exhibited lethargy, anorexia, icterus, a painful abdomen, fever, ruffled hair and H. felis infection [8]. This study describes, for the first time in Italy to our knowledge, a clinical and survival case of hepatozoonosis with an unusual presentation in a domestic cat.
An 11-year-old neutered European shorthair cat living in a cat household with > 30 individuals in a pre-alpine area at 700 masl (45°15′98’’N, 7°40′56’’E) and having free outdoor access was examined for its yearly routine veterinary check-up (day -7). A tick was found attached to the cat’s neck and was removed; then, the cat was treated with fipronil. The blood count presented some alterations in red blood cell, reticulocyte and monocyte total counts, and serum albumin was low (IDEXX Laboratories, Italy); no other remarkable findings were observed (Table 1). Five days later, the cat presented mild depression and loss of appetite; in a few days, a worsening of the clinical signs was observed, with anorexia, severe depression and vomiting. The cat was admitted to the hospital (day 0), and no particular findings were revealed during the physical examination such as fever, abdominal mass or pain. A complete hemato-biochemical profile (IDEXX Laboratories, Italy) and an abdominal ultrasound were performed.
Table 1.
Hemato-biochemical profiles from the first check-up (1 week before the surgery) to the recovery of the Hepatozoon-infected cat
| Reference ranges | Days | ||||
|---|---|---|---|---|---|
| − 7 | 0 | + 4 | + 13 | ||
| Blood count | |||||
| RBC | 7.1–11.5 M/µl | 6.9 | 7.0 | 5.3 | 5.0 |
| Hct | 28.2–52.7% | 30.4 | 28.8 | 20.9 | 19.5 |
| Hb | 10.3–16.2 g/dl | 10.8 | 10.3 | 7.9 | 7.3 |
| MCV | 39–56 fl | 44.4 | 41.4 | 39.3 | 39.3 |
| MCH | 12.6–16.5 pg | 15.8 | 14.8 | 14.8 | 14.7 |
| MCHC | 28.5–37.8 g/dl | 35.5 | 35.8 | 37.8 | 37.4 |
| Reticulocytes (total count) | K/µl | 115.1 | 25 | 10.1 | 32.2 |
| WBC | 3.9–19 K/µl | 15.7 | 20 | 15.6 | 14.2 |
| Neutrophils (total count) | 2.62–15.17 K/µl | 13.368 | 14.763 | 13.706 | 12.581 |
| Band neutrophils (total count) | 0–300/µl | 0 | 2195 | 0 | 0 |
| Lymphocytes (total count) | 0.85–5.85 K/µl | 1.443 | 1.795 | 0.749 | 0.895 |
| Monocytes (total count) | 0.04–0.53 K/µl | 0.706 | 1.197 | 1.124 | 0.653 |
| Eosinophils (total count) | 0.09–2.18 K/µl | 0.157 | 0 | 0.03 | 0.07 |
| Basophils (total count) | 0–0.1 K/µl | 0 | 0 | 0 | 0 |
| PLT | 155–641 K/µl | 259 | 266 | 211 | 183 |
| Notes |
Rouleaux (+++) Burr cells (++) Anisocytosis (+) Hepatozoon gamont in neutrophils Platelet aggregates |
Rouleaux (+) Heinz bodies (+) Doehle bodies Neutrophils: foamy (+) and basophilic (++) cytoplasm |
Rouleaux (+) Platelet aggregates |
||
| Instrument: Sysmex XT2000iV, Sysmex, Kobe, Japan | |||||
| Biochemical profile | |||||
| Glucose | 63–140 mg/dl | 85 | 80 | 84 | 97 |
| SDMA | 0–14 µg/dl | 12 | 12 | 19 | 11 |
| Creatinine | 0.9–2.3 mg/dl | 1.5 | 1.6 | 1.0 | 0.8 |
| BUN | 16–38 mg/dl | 23 | 67 | 31 | 18 |
| Phosphates | 2.48–6.81 mg/dl | 4.34 | 5.26 | 4.02 | 4.02 |
| Calcium | 8.82–11.62 mg/dl | 8.82 | 8.42 | 8.0 | 8.82 |
| Magnesium | 1.46–2.67 mg/dl | 2.19 | 3.4a | 2.19 | 1.7 |
| Sodium | 147–159 mmol/l | 149 | 140 | 149 | 154 |
| Potassium | 3.3–5.8 mmol/l | 4.8 | 4.8 | 5.0 | 4.5 |
| Chloride | 109–129 mmol/l | 115 | 94 | 116 | 122 |
| Total protein | 5.9–8.7 g/dl | 6.2 | 6.7 | 5.8 | 6.8 |
| Albumin | 2.7–4.4 g/dl | 2.4 | 2.5 | 1.9 | 2.2 |
| Globulins | 2.9–5.4 g/dl | 3.8 | 4.2 | 3.9 | 4.6 |
| Albumin/globulins | > 0.57 | 0.64 | 0.60 | 0.48 | 0.49 |
| ALT | 27–175 U/l | 38 | 31 | 51 | 34 |
| AST | 14–71 U/l | 29 | 83 | 49 | 26 |
| ALP | 12–73 U/l | 35 | 23 | 60 | 37 |
| GGT | 0–5 U/l | < 1 | 2 | < 1 | < 1 |
| Bilirubin (total) | 0–0.4 mg/dl | 0.2 | < 0.1 | 0.3 | 0.2 |
| Cholesterol | 86–329 mg/dl | 123 | 196 | 199 | 149 |
| Triglycerides | 21–432 mg/dl | 33 | 60 | 45 | 34 |
| Lipase | 0.1–45 U/l | nd | 21 | nd | 14 |
| CPK | 52–542 U/l | 111 | 2371 | 1156 | 313 |
| Urinary creatinine | mg/dl | 373 | 224 | nd | nd |
| Urinary total protein | mg/dl | 61.6 | 42.4 | nd | nd |
| PU/CU | < 0.33 | 0.2 | 0.2 | nd | nd |
| Fructosamine | 137–286 µmol/l | 148 | 305 | 150 | 150 |
| General notes | Vomiting, anorexia, stress, severe depression | Good general conditions | |||
| Instrument: Beckman-Coulter, Brea, CA, USA | |||||
RBC red blood cell count, Hct hematocrit, Hb hemoglobin, MCV mean corpuscular volume, MCH mean corpuscular hemoglobin, MCHC mean corpuscular hemoglobin concentration, WBC white blood cell count, PLT platelet count, SDMA symmetric dimethylarginine, BUN blood urea nitrogen, ALT alanine transferase, AST aspartate transferase, ALP alkaline phosphatase, GGT gamma-glutamyl transferase, CPK creatine phosphokinase, PU/CU urine protein to creatinine ratio, nd Not done
aHemolytic serum
The blood count showed an inflammatory leukogram with left shift and monocytosis, and the biochemical profile presented several alterations (i.e. electrolytes, CPK, AST, fructosamine) reported in Table 1. Microscopy of May Grunwald Giemsa-stained blood smear revealed single ovoid inclusions in neutrophils attributable to Hepatozoon gamonts (11.2 × 5.1 μm, with an ovoid central nucleus, Fig. 1); subsequently, the protozoan parasite was confirmed at the genera level (i.e. Hepatozoon spp.) on a blood sample by PCR targeting the 18S-rRNA gene with a cycle threshold (Ct) of 36.3 (IDEXX Laboratories, Germany).
Fig. 1.
A gamont of Hepatozoon sp. in a granulocyte. The blood smear was stained with May-Grünwald Giemsa
Additionally, the cat tested negative for feline immunodeficiency virus (FIV) antibodies and feline leukemia virus (FeLV) antigens (SNAP FIV-FeLV Combo test, IDEXX Laboratories, Inc.). The results were also confirmed by molecular investigations targeting the FeLV proviral DNA (IDEXX Laboratories, Germany). The abdominal ultrasound identified an intestinal intussusception; thus, the cat was urgently admitted to the operating room for a laparotomy.
At surgery, a jejunal endoluminal pedunculated nodule of approximately 1.5 cm, almost occluding the intestinal lumen and causing intussusception, was found. The biochemical parameters improved and normalized within 13 days after surgery (Table 1). The cat was administered a 30-day regimen of oral doxycycline at 5 mg/kg bid. Blood PCR was performed 10 days after the end of doxycycline administration (day + 40), and the result was positive (Ct = 36.9) for the targeted Hepatozoon DNA (IDEXX Laboratories, Germany); 1 month later (day + 70), it finally became negative. The time line of the events and their brief descriptions are reported in Fig. 2.
Fig. 2.
Descriptive time line of clinical conditions, laboratory analyses and treatment of Hepatozoon-infected cat
No other vector-borne pathogens were tested because the hemato-biochemical profile and the rapid worsening of clinical conditions were suggestive of acute and severe disease; it was decided to wait for the clinical recovery of the cat before testing for other pathogens; then, since the cat recovered quickly, no other investigations for VBDs were done.
The intestinal nodule was submitted to histopathological and molecular investigations (University of Padova). Tissue sections revealed a severe inflammatory reaction characterized by chronic ulcerative enteritis with polypoid proliferation and severe lymphangiectasia. Many protozoal inclusions were revealed within the enterocytes of the intestinal villi and near the lumen (Fig. 3). The protozoa were roundish, of variable size (with an average size of 15 to 25 µm) and characterized by dark basophilic-staining small nuclei. These forms were referred to as parasitic inclusions of Hepatozoon spp. Away from the nodule, along the surgical section in the healthy intestinal tissue, no protozoal inclusions in the enterocytes were observed. Subsequently, to identify the protozoa affecting the intestinal tissue and causing the local host reaction and the nodule, conventional PCR was performed, targeting the 18S-rRNA of Hepatozoon spp. with primers described by Tabar et al. [18]. A positive (sequenced DNA of naturally infected cat) and negative (no DNA added) control was added to each PCR. The PCR products were sequenced (Macrogen, Spain) in both directions with the same primers used in PCR. The sequences were compared with those already deposited in GenBank by BLAST software (https://blast.ncbi.nlm.nih.gov/Blast.cgi). Sequence analysis revealed the presence of Hepatozoon silvestris (100% homology, accession number: KY649445.1).
Fig. 3.

a–b Histological sections of cat intestinal nodule: protozoan inclusions in the enterocytes (black circles). Hematoxylin-eosin staining. Bar 40 µm
Epidemiological studies reported the detection of H. silvestris DNA in wildcats from Bosnia and Herzegovina [3, 21] and in domestic cats from northeastern [10], southern Italy [9] and central Europe [7, 11]. This study describes the case of a cat coming from a hilly area in northwestern Italy close to the Swiss borders, where a fatal case of myocarditis caused by H. silvestris in a cat was recently reported [7] and where the presence of wild felids such as the European lynx is frequently described [22, 23]. European lynx and wildcats are already reported as potential reservoirs of several parasites for domestic cat populations sharing the same context of living [10, 21, 24]. Even though in the northwestern Italian regions the presence of lynx and wildcats is rarely observed, the possibility that these animals cross the Alps from highly endemic territories such as neighboring France and Switzerland is probable, as already demonstrated in recent years [23]. The pre-alpine area where the case report took place is close to the French border, and the outdoor lifestyle of the cat suggests exposure to the risk of sharing parasites and arthropod vectors with the sylvatic environment.
Recent studies reported the identification of H. felis DNA in Rhipicephalus sanguineus sensu lato and Rhipicephalus turanicus ticks [12, 14, 25] and H. silvestris DNA in Ixodes ricinus ticks [15]. This is not sufficient to define the competence role of these ticks as a biological vector. Since I. ricinus, already known as the forest tick or castor bean tick, is the most widespread tick in European wild areas, it might be considered to have a potential role in the transmission of H. silvestris [7, 13, 26]. The presence of the tick on the cat’s neck during the yearly routine examination (day -7) suggests that exposure to arthropod activity and the ingestion of infected ticks by the cat during fur grooming are possible. Unfortunately, the tick was removed and not conserved; thus, morphological identification and molecular investigations for detecting Hepatozoon DNA were not possible; in addition, no other ticks were found after the cat was treated with fipronil. The predation of infected prey, e.g. mostly rodents, was considered another possible route of Hepatozoon transmission [2, 5].
In domestic and wild cats, Hepatozoon causes a generally subclinical inflammation of skeletal muscles and myocardium [2, 19, 20] as well as elevated values of CPK enzyme in the majority of affected subjects [2, 16, 17]. This finding was observed in our case study, suggesting a potential involvement of skeletal muscles. In cats, the level of parasitemia is generally low and not correlated with the infection burden and the presence of meronts in muscle tissues, and the reason is not yet clear [16, 19]. Neutrophils containing gamonts are usually < 1% [2, 16], as observed in our blood smear evaluation. Specifically, rare gamonts were identified only in the blood smear performed during hospitalization; in all subsequent blood smears, not one gamont was observed.
The intestinal intussusception was generated by a sessile endoluminal nodule, which could have been due to (1) the inflammatory local response to the parasite's penetration through the intestinal mucosa and/or (2) an inflammatory process that was already present where the Hepatozoon found a good substrate for replicating. Considering the H. canis life cycle already described by Baneth et al. [4], the parasitic inclusions (15–25 µm) found in the histological sections of the sessile nodule, even if smaller than those reported in the literature, could be referred to as protozoan replicative forms such as meronts of H. silvestris, suggesting that the nodule was probably the first site of protozoan replication. In addition, the altered values of CPK and AST at day 0 suggested light skeletal muscle damage (i.e. subclinical myositis), as previously reported in cats with hepatozoonosis [16, 17], even if, in this particular case, inflammation of the intestinal muscle layer could be hypothesized. At day 0 circulating sodium and chloride concentrations were low probably because of vomiting. In addition, fructosamine concentration was increased and normalized a few days later; although unproven, it is possible that longstanding stress of the disease temporarily and mildly increased glucose levels. The improvement of CPK immediately after surgery supports the hypothesis that the nodule was the source of the clinical signs. Finally, doxycycline therapy seemed to be helpful for the complete recovery of the cat. Other treatment protocols are reported in cats in the literature such as the combination of doxycycline with primaquine, oxytetracycline with primaquine and imidocarb dipropionate with doxycycline [8, 17]. Actually, there were no controlled studies on the treatment of feline hepatozoonosis, and all information is anecdotal with debatable results. The choice to adopt only doxycycline was due to the difficulties of (i) the off-label use of imidocarb dipropionate in Italy and (ii) finding primaquine on the market easily and/or quickly.
Unfortunately, further histological investigations from other muscle sections and organs before and after treatment would have been useful to evaluate the skeletal muscle involvement, infection burden and efficacy of the treatment protocol but would have been unethical. In addition, the cat was treated to ensure its complete recovery without considering the novelty of Hepatozoon infection and the scientific publication.
Further investigations are needed to improve the scientific knowledge on Hepatozoon infections in felids, particularly in domestic cats, to prevent severe and potentially fatal clinical cases. Increased knowledge regarding the Hepatozoon life cycle in wild and domestic felids as long as arthropod vectors are involved would surely be useful for the adoption of adequate preventative measures in cats.
In conclusion, contrary to the other European case [7] in which H. silvestris caused fatal myocarditis in a domestic cat, in this report, the patient recovered completely after surgical removal of the “parasitic” nodule and monthly doxycycline therapy. The intestinal intussusception caused the sudden worsening of the clinical conditions, and surgical resolution was necessary to save the cat. However, the intestinal nodule was probably the result of a local inflammatory reaction to limit the Hepatozoon penetration, and it became the first site of protozoan replication; its surgical removal helped the cat to rapidly recover. Despite the unusual clinical presentation of this case, surgery should not to be the treatment of choice in every hepatozoonotic infections with intestinal signs and/or ultrasonographic abnormalities. Feline hepatozoonosis is an emerging vector-borne disease, and considering the recent reports of symptomatic cases, monitoring in cat populations is strongly advised.
Acknowledgements
We are grateful to Dr. Valter Fiore for his enthusiasm and help in chronologically reconstructing the facts of this particular clinical case.
Abbreviations
- CPK
Creatine phosphokinase
- AST
Aspartate transferase
- Ct
Cycle threshold
- FIV
Feline immunodeficiency virus
- FeLV
Feline leukemia virus
- VBDs
Vector-borne diseases
Author contributions
VF and GSa followed the clinical case and provided all data regarding the cat from anamnesis to recovery; SMa performed hemato-biochemical analyses; LC and MEG performed histopathological evaluations; SMo, MG and GD performed DNA extraction and molecular analyses on nodule sections; GSi and EZ conceived and revised the manuscript; GSi wrote the manuscript draft. All authors read and approved the final manuscript.
Funding
This study was funded by the Department of Animal Medicine, Production and Health, University of Padova, Italy (BIRD193835, 2019).
Availability of data and materials
All data analyzed during this study are included in this published article.
Declarations
Ethics approval and consent to participate
All procedures were performed within the routine veterinary activity.
Consent for publication
Not applicable.
Competing interests
The authors declare that they have no competing interests.
Footnotes
Publisher's Note
Springer Nature remains neutral with regard to jurisdictional claims in published maps and institutional affiliations.
Contributor Information
Giulia Simonato, Email: giulia.simonato@unipd.it.
Vittoria Franco, Email: vittoria.franco@anicura.it.
Giovanna Salvatore, Email: novara.chirurgia@anicura.it.
Simone Manzocchi, Email: simone-manzocchi@idexx.com.
Giorgia Dotto, Email: giorgia.dotto@unipd.it.
Simone Morelli, Email: smorelli@unite.it.
Marika Grillini, Email: marika.grillini@phd.unipd.it.
Laura Cavicchioli, Email: laura.cavicchioli@unipd.it.
Maria Elena Gelain, Email: mariaelena.gelain@unipd.it.
Eric Zini, Email: eric.zini@unipd.it.
References
- 1.Smith TG. The genus Hepatozoon (Apicomplexa: Adeleina) J Parasitol. 1996;82:565–585. doi: 10.2307/3283781. [DOI] [PubMed] [Google Scholar]
- 2.Baneth G. Perspectives on canine and feline hepatozoonosis. Vet Parasitol. 2011;181:3–11. doi: 10.1016/j.vetpar.2011.04.015. [DOI] [PubMed] [Google Scholar]
- 3.Hodžić A, Alić A, Prašović S, Otranto D, Baneth G, Dusher GG. Hepatozoon silvestris sp. nov.: morphological and molecular characterization of a new species of Hepatozoon (Adeleorina: Hepatozoidae) from the European wild cat (Felis silvestris silvestris) Parasitology. 2017;144:650–661. doi: 10.1017/S0031182016002316. [DOI] [PMC free article] [PubMed] [Google Scholar]
- 4.Baneth G, Samish M, Shkap V. Life cycle of Hepatozoon canis (Apicomplexa: Adeleorina: Hepatozoidae) in the tick Rhipicephalus sanguineus and domestic dog (Canis familiaris) J Parasitol. 2007;93:283–299. doi: 10.1645/GE-494R.1. [DOI] [PubMed] [Google Scholar]
- 5.Johnson EM, Panciera RJ, Allen KE, Sheets ME, Beal JD, Ewing SA, Little SE. Alternate pathway of infection with Hepatozoon americanum and the epidemiologic importance of predation. J Vet Intern Med. 2009;23:1315–1318. doi: 10.1111/j.1939-1676.2009.0375.x. [DOI] [PubMed] [Google Scholar]
- 6.Baneth G, Sheiner A, Eyal O, Hahn S, Beaufils JP, Anug Y, Talmi-Frank D. Redescription of Hepatozoon felis (Apicomplexa: Hepatozoidae) based on phylogenetic analysis, tissue and blood form morphology, and possible transplacental transmission. Parasit Vectors. 2013;6:102. doi: 10.1186/1756-3305-6-102. [DOI] [PMC free article] [PubMed] [Google Scholar]
- 7.Kegler K, Nufer U, Alic A, Posthaus H, Olias P, Basso W. Fatal infection with emerging apicomplexan parasite Hepatozoon silvestris in a domestic cat. Parasit Vectors. 2018;11:428. doi: 10.1186/s13071-018-2992-4. [DOI] [PMC free article] [PubMed] [Google Scholar]
- 8.Basso W, Görner D, Globokar M, Keidel A, Pantchev N. First autochthonous case of clinical Hepatozoon felis infection in a domestic cat in Central Europe. Parasitol Intl. 2019;72:101945. doi: 10.1016/j.parint.2019.101945. [DOI] [PMC free article] [PubMed] [Google Scholar]
- 9.Giannelli A, Latrofa MS, Nachum-Biala Y, Hodžić A, Greco G, Attanasi A, Annoscia G, Otranto D, Baneth G. Three different Hepatozoon species in domestic cats from southern Italy. Ticks Tick Borne Dis. 2017;8:721–724. doi: 10.1016/j.ttbdis.2017.05.005. [DOI] [PubMed] [Google Scholar]
- 10.Grillini M, Simonato G, Tessarin C, Dotto G, Traversa D, Cassini R, Marchiori E. Frangipane di Regalbono A. Cytauxzoon sp. and Hepatozoon spp. in domestic cats: a preliminary study in North-eastern Italy. Pathogens. 2021;10:1214. doi: 10.3390/pathogens10091214. [DOI] [PMC free article] [PubMed] [Google Scholar]
- 11.Schäfer I, Kohn B, Nijhof AM, Müller E. Molecular detection of Hepatozoon species infections in domestic cats living in Germany. J Feline Med Surg. 2021;16:1098612X211055680. doi: 10.1177/1098612X211055680. [DOI] [PMC free article] [PubMed] [Google Scholar]
- 12.Bhusri B, Sariya L, Mongkolphan C, Suksai P, Kaewchot S, Changbunjong T. Molecular characterization of Hepatozoon felis in Rhipicephalus sanguineus ticks infested on captive lions (Panthera leo) J Parasit Dis. 2017;41:903–907. doi: 10.1007/s12639-017-0902-x. [DOI] [PMC free article] [PubMed] [Google Scholar]
- 13.Duplan F, Davies S, Filler S, Abdullah S, Keyte S, Newbury H, Helps CR, Wall R, Tasker S. Anaplasma phagocytophilum, Bartonella spp., haemoplasma species and Hepatozoon spp. in ticks infesting cats: a large-scale survey. Parasit Vectors. 2018;11:201. doi: 10.1186/s13071-018-2789-5. [DOI] [PMC free article] [PubMed] [Google Scholar]
- 14.Orkun Ő, Emir H. Identification of tick-borne pathogens in ticks collected from wild animals in Turkey. Parasitol Res. 2020;119:3083–3091. doi: 10.1007/s00436-020-06812-2. [DOI] [PubMed] [Google Scholar]
- 15.Hornok S, Boldogh SA, Takács N, Kontschán J, Szekeres S, Sós E, Sándor AD, Wang Y, Tuska-Szalay B. Molecular epidemiological study on ticks and tick-borne protozoan parasites (Apicomplexa: Cytauxzoon and Hepatozoon spp.) from wild cats (Felis silvestris), Mustelidae and red squirrels (Sciurus vulgaris) in central Europe, Hungary. Parasit Vectors. 2022;15:174. doi: 10.1186/s13071-022-05271-1. [DOI] [PMC free article] [PubMed] [Google Scholar]
- 16.Baneth G, Aroch I, Tal N, Harrus S. Hepatozoon species infection in domestic cats: a retrospective study. Vet Parasitol. 1998;79:123–133. doi: 10.1016/s0304-4017(98)00160-5. [DOI] [PubMed] [Google Scholar]
- 17.Lloret A, Addie DD, Boucraut-Baralon C, Egberink H, Frymus T, Gruffydd-Jones T, Hartmann K, Horzinek MC, Hosie MJ, Lutz H, Marsilio F, Pennisi MG, Radford AD, Thiry E, Truyen U, Möstl K, European Advisory Board on Cat Diseases Hepatozoonosis in cats: ABCD guidelines on prevention and management. J Feline Med Surg. 2015;17:642–4. doi: 10.1177/1098612X15589879. [DOI] [PMC free article] [PubMed] [Google Scholar]
- 18.Tabar MD, Altet L, Francino O, Sanchez A, Ferrer Roura X. Vector-borne infections in cats: molecular study in Barcelona area (Spain) Vet Parasitol. 2008;151:332–336. doi: 10.1016/j.vetpar.2007.10.019. [DOI] [PubMed] [Google Scholar]
- 19.Klopfer U, Nobel TA, Neumann F. Hepatozoon-like parasite (schizonts) in the myocardium of the domestic cat. Vet Pathol. 1973;10:185–190. doi: 10.1177/030098587301000301. [DOI] [PubMed] [Google Scholar]
- 20.Kubo M, Miyoshi N, Yasuda N. Hepatozoonosis in two species of Japanese wild cat. J Vet Med Sci. 2006;68:833–837. doi: 10.1292/jvms.68.833. [DOI] [PubMed] [Google Scholar]
- 21.Hodžić A, Alić A, Duscher GG. High diversity of blood-associated parasites and bacteria in European wild cats in Bosnia and Herzegovina: a molecular study. Ticks Tick Borne Dis. 2018;9:589–593. doi: 10.1016/j.ttbdis.2018.01.017. [DOI] [PubMed] [Google Scholar]
- 22.Europe Commission. Status of large carnivore populations in Europe 2012–2016. https://ec.europa.eu/environment/nature/conservation/species/carnivores/conservation_status.htm. Accessed 3 Oct 2022.
- 23.KORA foundation. Status and Conservation of the Alpine Lynx Population. 2020. https://www.kora.ch/en/species/lynx/distribution. Accessed 3 Oct 2022.
- 24.Traversa D, Morelli S, Di Cesare A, Diakou A. Felid cardiopulmonary nematodes: dilemmas solved and new questions posed. Pathogens. 2021;10:30. doi: 10.3390/pathogens10010030. [DOI] [PMC free article] [PubMed] [Google Scholar]
- 25.Mumcuoglu KY, Arslan-Akveran G, Aydogdu S, Karasartova D, Koşar A, Savci U, Keskin A, Taylan-Ozkan A. Pathogens in ticks collected in Israel: II. Bacteria and protozoa found in Rhipicephalus sanguineus sensu lato and Rhipicephalus turanicus. Ticks Tick Borne Dis. 2022;13:101986. doi: 10.1016/j.ttbdis.2022.101986. [DOI] [PubMed] [Google Scholar]
- 26.Hamšíková Z, Silaghi C, Rudolf I, Venclíková K, Mahríková L, Slovák M, Mendel J, Blažejová H, Berthová L, Kocianová E, Hubálek Z, Schnittger L, Kazimírová M. Molecular detection and phylogenetic analysis of Hepatozoon spp. in questing Ixodes ricinus ticks and rodents from Slovakia and Czech Republic. Parasitol Res. 2016;115:3897–904. doi: 10.1007/s00436-016-5156-5. [DOI] [PubMed] [Google Scholar]
Associated Data
This section collects any data citations, data availability statements, or supplementary materials included in this article.
Data Availability Statement
All data analyzed during this study are included in this published article.


